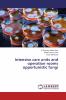
Intensive care units and operation rooms opportunistic fungi

English
Paperback
₹4364
(All inclusive*)
Delivery Options
Please enter pincode to check delivery time.
*COD & Shipping Charges may apply on certain items.
Review final details at checkout.
Looking to place a bulk order? SUBMIT DETAILS
About The Book
Description
Author
it is a unique work dealing with fungal contamination in intensive care units and operation rooms. An interesting subject rarely touched by microbiologist. Most of the previous researches dealt with bacterial contamination. In this piece of work you will find interesting records on mycology mycotoxins enzymes that might be enhancing the severeness of opportunistic fungi to invade nosocomial and immunosupressive patients. It also embraced a new technique of using chlorella vulgaris as a sensitive andreliable biological assay.
Delivery Options
Please enter pincode to check delivery time.
*COD & Shipping Charges may apply on certain items.
Review final details at checkout.
Details
ISBN 13
9783659611124
Publication Date
-22-09-2015
Pages
-112
Weight
-163 grams
Dimensions
-150x220x6.35 mm